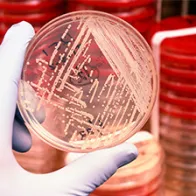
Antibiotic resistant bacteria. © Science Photo Library

Antimicrobial consumption and resistance in bacteria from humans and food-producing animals (JIACRA IV – 2019−2021)
Executive Summary
The fourth joint inter‐agency report on integrated analysis of antimicrobial consumption (AMC) and the occurrence of antimicrobial resistance (AMR) in bacteria from humans and food‐producing animals (JIACRA) addressed data obtained by the Agencies' EU‐wide surveillance networks for 2019–2021. The analysis also sought to identify whether significant trends in AMR and AMC were concomitant over 2014–2021. AMC in both human and animal sectors, expressed in mg/kg of estimated biomass, was compared at country and European level. In 2021, the total AMC was assessed at 125.0 mg/kg of biomass for humans (28 EU/EEA countries, range 44.3–160.1) and 92.6 mg/kg of biomass for food-producing animals (29 EU/EEA countries, range 2.5–296.5).
Between 2014 and 2021, total AMC in food-producing animals decreased by 44%, while in humans, it remained relatively stable. Univariate and multivariate analyses were performed to study associations between AMC and AMR for selected combinations of bacteria and antimicrobials. Positive associations between consumption of certain antimicrobials and resistance to those substances in bacteria from both humans and food-producing animals were observed.
For certain combinations of bacteria and antimicrobials, AMR in bacteria from humans was associated with AMR in bacteria from food‐producing animals which, in turn, was related to AMC in animals. The relative strength of these associations differed markedly between antimicrobial class, microorganism and sector.
For certain antimicrobials, statistically significant decreasing trends in AMC and AMR were concomitant for food-producing animals and humans in several countries over 2014-2021. Similarly, a proportion of countries that significantly reduced total AMC also registered increasing susceptibility to antimicrobials in indicator E. coli from food- producing animals and E. coli originating from human invasive infections (i.e., exhibited ‘complete susceptibility’ or ‘zero resistance’ to a harmonised set of antimicrobials).
Overall, the findings suggest that measures implemented to reduce AMC in food-producing animals and in humans have been effective in many countries. Nevertheless, these measures need to be reinforced so that reductions in AMC are retained and further continued, where necessary. This also highlights the importance of measures that promote human and animal health, such as vaccination and better hygiene, thereby reducing the need for use of antimicrobials.
Antimicrobial consumption and resistance in bacteria from humans and food- producing animals (JIACRA IV – 2019−2021)
English (23.52 MB - PDF)Read more

This is a summary of the fourth joint inter-agency report on integrated analysis of antimicrobial consumption and occurrence of antimicrobial resistance in bacteria from humans and food-producing animals in the European Union (JIACRA IV – 2019–2021).
Simplified summary of JIACRA IV 2019-2021
English (599.29 KB - PDF)
Countries that have decreased their consumption of antibiotics in both animals and humans have seen a reduction in antibiotic-resistant bacteria.
Share this page



